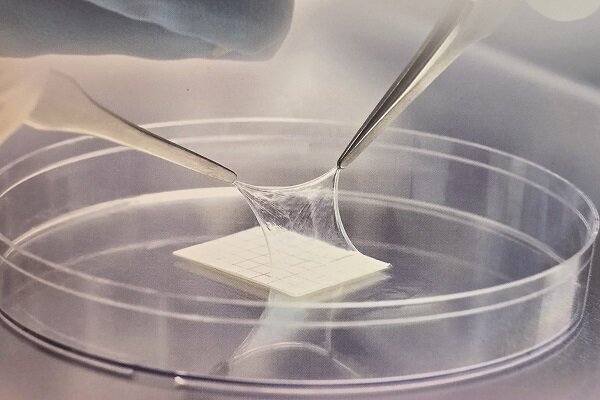

به گزارش خبرنگار مهر، دکتر مرتضی ضرابی امروز در نشست خبری که به مناسبت روز جهانی خون بندناف و معرفی «محصول زخمپوش بیولوژیک و خدمات ذخیرهسازی پالپ دندان» در شرکت فناوری بنیاختههای رویان برگزار شد، با اشاره به نامگذاری روزی به عنوان روز جهانی خون بند ناف گفت: این روز برای جلب توجه کشورها به خون بندناف که ضمائم ارزشمندی است ولی به عنوان زباله بیولوژیک دور ریخته میشوند، نامگذاری شده است.
وی در مورد سلولهای بنیادی گفت: به هر سلولی که قدرت خودنوزایی داشته باشد و بتواند به سلولهای دیگر تمایز یابد، سلولهای بنیادی گفته میشود. دو نوع سلولهای بنیادی خونساز و غیر خون ساز یا مزانشیمی وجود دارد. منابع سلولهای بنیادی خونساز، خون محیطی، مغز استخوان و خون بند ناف است چه هر سه منبع در مرکز بانک خون بند ناف رویان وجود دارد.
مدیرعامل شرکت فناوری بنیاختههای رویان در مورد منابع سلولهای بنیادی مزانشیمی گفت: بافت بندناف، بافت چربی و پالپ دندان؛ سه منبع سلولهای بنیادی مزانشیمی هستند.
وی در مورد کاربرد سلولهای بنیادی توضیح داد: این سلولها میتوانند در درمان بیماریهای مختلف تاثیر گذار باشند. سلولهای بنیادی خون ساز در بیماری خونی مثل سرطانهای خون، تالاسمی، نقص سیستم ایمنی و ... کاربرد دارند. سلولهای بنیادی مزانشیمی در بیماریهای عصبی و ارتوپدی در حال کارآزمایی بالینی است و محققان بسیار امیدوارند در آینده بتواند از آن استفاده کرد.
به گفته ضرابی؛ در حال حاضر بانک جامع خون بندناف رویان را به عنوان محصولات زیستی میشناسند ولی در این بانک علاوه بر بندناف مغز استخوان، خون محیطی، سلولهای مزانشیمی بندناف و پالپ دندان در قالب بانک امکان ذخیرهسازی وجود دارد.
وی افزود: از سرم خون بند ناف نیز بانکهای دیگری داریم. همچنین بانک اطلاعات ژنتیکی یا HLA وجود دارد و این فرصت را فراهم کرده تا برای پیوند نمونه مناسب را پیدا کنیم. تنها بانک جامع کشور هستیم که این محصولات را کنار هم ذخیره سازی کنیم.
مدیرعامل شرکت فناوری بنیاختههای رویان در مورد بانک خون بندناف گفت: دستاورد امروز ما ذخیره ۲۳۰ هزار نمونه خون بندناف است. بزرگترین ظرفیت را در سطح منطقه داریم و این امکان وجود دارد با احتمال بیشتر نمونه مناسب برای پیوند پیدا کنیم.
وی خاطر نشان کرد: ما امروز از کشورهای همسایه و اروپایی نیز نمونه خون بندناف داریم به این صورت که زایمان در کشورهای دیگر انجام شده و بند ناف به کشور منتقل شده است.
ضرابی با بیان اینکه بانک خون رویان در نقشه جهانی ثبت شده است، ادامه داد: امیدواریم بتوانیم ارتباط بینالمللی با بانکهای بینالمللی برقرار کنیم تا امکان انتقال نمونهها نیز فراهم شود.
وی در مورد بومیسازی دانش فنی گفت: در حال حاضر دانش فنی دستیابی به منابع، امکان تمایز، استفاده تحقیقاتی و درمانی و نگهداری طولانی مدت بیش از ۲۰ سال در این بانک بومیسازی شده است.
ذخیره سازی خون بند ناف برای بیش از ۲۰ سال
مدیرعامل شرکت فناوری بنیاختههای رویان در مورد زمان نگهداری محصولات بانک خون بندناف گفت: در حال حاضر نمونهها را میتوان در دمای منفی ۱۹۶ برای مدت نامحدود نگهداری کرد. استانداردهای جهانی عنوان میکنند تا ۲۵ سال قابل نگهداری هستند و در صورت افزایش تجربه افزایش میتوانیم تا ۳۰ سال هم نگهداری کنیم.
وی خاطر نشان کرد: به واسطه دستیابی به این دانش فنی با کشورهای همسایه قرارداد امضا کردیم که بانک خون بندناف را در کشورهای منطقه راهاندازی کنیم.
ضرابی در مورد پالایشگاه محصولات زایمانی گفت: در پالایشگاه محصولات زایمانی، ضمائم زایمانی و بافتهایی که بعد از زایمان دور ریخته میشود پالایش میشود. این موضوع جدیدی است و در دنیا بدون نظیر است و در آن میتوان خون بندناف، بافت بندناف، پرده جنینی، مایع جنینی و جفت را پالایش کرد. تجربه ثابت کرده اینها زباله نیست.
مدیرعامل شرکت فناوری بنیاختههای رویان با اشاره به تولید اولین محصول پالایشگاه محصولات زایمانی گفت: پرده آمنیونیک به عنوان اولین محصول پالایشگاه تولید شده و امکان عرضه آن فراهم شده است. پیشبینی میکنیم بیش از ۲۰ محصول بتوانیم در پالایشگاه فرآوری کنیم.
تولید پانسمان زخم از محصولات زایمانی
وی افزود: این محصول با نام «امیکر» اولین محصولی است که پروانه تولید و بهرهبرداری از وزارت بهداشت دریافت کرده است و میتواند در ترمیم و بازسازی بافت و زخم سوختگی و زخم جراحی مورد استفاده قرار گیرد. این محصول به صورت یک پانسمان خشک در بسته بندیهای مختلف آماده شده و اولین محصول پالایشگاه است.
هزینه ۴۰ هزار یورویی وارد کردن نمونه سلول بنیادی بندناف
مدیرعامل شرکت فناوری بنیاختههای رویان با اشاره به صرفهجویی ارزی از طریق ذخیرهسازی سلولهای بنیادی بندناف گفت: در صورتی که نمونه سلول بنیادی مناسب با ویژگیهای ژنتیکی یک بیمار برای پیوند، در بانکهای داخلی وجود نداشته باشد، وزارت بهداشت ملزم به تهیه نمونه از بانکهای جهانی است و برای تهیه هر نمونه از سلولهای بنیادی بند ناف از کشورهای دیگر بیش از ۴۰ هزار یورو باید هزینه کند.
وی تاکید کرد: همچنین هر چقدر ما ظرفیت بانکهای سلول بنیادی را افزایش دهیم شانس پیدا کردن نمونه مناسب برای بیماران افزایش خواهد داشت. ما سالانه ۲۰ تا ۲۵ هزار نمونه خون بندناف ذخیره میکنیم. همچنین علاوه بر بانک خون بندناف رویان سازمان انتقال خون هم بانک خون بند ناف دارد. با این وجود سال گذشته ۱۵ نمونه از سایر کشورها وارد کشور شد.
به گفته ضرابی این پالایشگاه تا پایان سال در پارک پردیس راهاندازی میشود. این محصول برای ترمیم روند و زخمهای سوختگی، زخم دیابتی، زخم بستر و ... استفاده میشود.
وی خاطر نشان کرد: ما در قدم اول پیشبینی تولید ۱۰۰۰ قطعه در ماه را داشتیم ولی در حال حاضر با درخواست ۴ برابری مواجه شدیم که در مراکز سوختگی استفاده شود. همچنین این محصول امکان صادرات و قدرت رقابت با محصولات خارجی دارد.
وی با بیان اینکه این محصول یک سد زیستی برای ترمیم زخم است، ادامه داد: همچنین قابلیت جذب توسط بدن را دارد و بدون عارضه و حساسیت، قدرت اثرگذاری ۳ تا ۵ روزه دارد.












